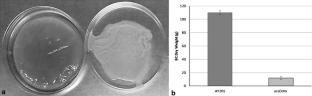

Abstract
The acsD gene is involved in cellulose biosynthesis among the Acetobacter species. In the current study, we created an acsD disruption mutant in the acsABCD cellulose synthase operon of Gluconacetobacter xylinus and characterized the resulting cellulose to aid in providing insight into the function of the acsD gene. Both the wild type G. xylinus AY201 (derivative of Gluconacetobacter hansenii ATCC 23769) and the acsD disruption mutant produced crystalline cellulose I microfibrils. The cellulose produced by both appeared to be synthesized from an aggregate of pores known as a linear terminal complex; however the total cellulose synthesized was 10 % that of the wild type G. xylinus AY201. TEM observations of the acsD disruption mutant confirmed that microfibrils and bundles of microfibrils were similar in size to the G. xylinus AY201 wild type; however, the final ribbon dimensions were narrower (53.4 ± 13.1 nm wt, vs. 28.2 ± 8.2 nm). Additional TEM observations of the mutant cells incubated at 4 °C revealed an abnormal linear terminal complex orientation whereby the resulting band material could be observed in a transverse orientation as well as longitudinally to the long axis of the cell. Taken together, these data strongly suggest that acsD aids in the proper orientation of the linear terminal complexes along the longitudinal axis of the cell indicating the AcsD protein is involved in the final level of the hierarchical assembly of cellulose resulting in highly efficient cellulose synthesis.

Similar content being viewed by others
References
Amikam D, Galperin MY (2006) PilZ domain is part of the bacterial c-di-GMP binding protein. Bioinformatics 22:3–6
Benziman M, Haigler CH, Brown RM Jr, White AR, Cooper KM (1980) Cellulose biogenesis: polymerization and crystallization are coupled processes in Acetobacter xylinum. Proc Natl Acad Sci USA 77:6678–6682
Blanton RL, Fuller D, Iranfar N, Grimson MJ, Loomis WF (2000) The cellulose synthase gene of Dictyostelium. Proc Natl Acad Sci USA 97:2391–2396
Brown RM Jr (1985) John Innes Symposium. Cellulose microfibril assembly and orientation: recent developments. J Cell Sci Suppl 2:13–32
Brown RM Jr (1996) The biosynthesis of cellulose. Pure Appl Chem A33:1345–1373
Brown RM Jr, Willison JHM, Richardson CL (1976) Cellulose biosynthesis in Acetobacter xylinum: visualization of the site of synthesis and direct measurement of the in vivo process. Proc Natl Acad Sci USA 73:4565–4569
Cousins SK, Brown RM Jr (1995) Cellulose I microfibril assembly: computational molecular mechanics energy analysis favours bonding by van der Waals forces as the initial step in crystallization. Polymer 36:3885–3888
Cousins SK, Brown RM Jr (1997) Photoisomerization of a dye-altered β-1,4 glucan sheet induces the crystallization of a cellulose-composite. Polymer 38:903–912
Czaja W, Romanovicz D, Brown RM Jr (2004) Structural investigations of microbial cellulose produced in stationary and agitated culture. Cellulose 11:403–411
Deng Y, Nagachar N, Xiao C, Tien M, Kao T (2013) Identification and characterization of non-cellulose-producing mutants of Gluconacetobacter hansenii generated by Tn 5 transposon mutagenesis. J Bacteriol 195:5072–5083
Haigler CH, Brown RM Jr, Benziman M (1980) Calcofluor white ST alters the in vivo assembly of cellulose microfibrils. Science 210:903–906
Haigler CH, White AR, Brown RM Jr, Cooper KM (1982) Alteration of in vivo cellulose ribbon assembly by carboxymethylcellulose and other cellulose derivatives. J Cell Biol 94:64–69
Hesse S, Kondo T (2005) Behavior of cellulose production of Acetobacter xylinum in 13C-enriched cultivation media including movements on nematic ordered cellulose templates. Carbohydr Polym 60:457–465
Hirai A, Tsuji M, Horii F (1997) Communication: culture conditions producing structure entities composed of cellulose I and II in bacterial cellulose. Cellulose 4:239–245
Hirai A, Tsuji M, Horii F (2002) TEM study of band-like cellulose assemblies produced by Acetobacter xylinum at 4 °C. Cellulose 9:105–113
Hu SQ, Gao YG, Tajima K, Sunagawa N, Zhou Y, Kawano S, Fujiwara T, Yoda T, Shimura D, Satoh Y, Munekata M, Tanaka I, Yao M (2010) Structure of bacterial cellulose synthase subunit D octamer with four inner passageways. Proc Natl Acad Sci USA 107:17957–17961
Iyer P, Catchmark J, Brown N, Tien M (2011) Biochemical localization of a protein involved in synthesis of Gluconacetobacter hansenii cellulose. Cellulose 18:739–747
Iyer P, Lui Y, Deng Y, McManus J, Kao T, Tien M (2013) Processing of cellulose synthase (AcsAB) from Gluconacetobacter hansenii 23769. Arch Biochem Biophys 529:92–98
Kimura S, Chen HP, Saxena IM, Brown RM Jr (2001) Localization of c-di-GMP-binding protein with the linear terminal complexes of Acetobacter xylinum. J Bacteriol 183:5668–5674
Koizumi S, Yue Z, Tomita Y, Kondo T, Iwase H, Yamaguchi D, Hashimoto T (2008) Bacterium organizes hierarchical amorphous structure in microbial cellulose. Eur Phys J E26:137–142
Koizumi S, Tomita Y, Kondo T, Hasimoto T (2009) What factors determine hierarchical structure of microbial cellulose: interplay among physics, chemistry and biology. Macromol Symp 279:110–118
Kondo T, Nojiri M, Hishikawa Y, Togawa E, Romanovicz D, Brown RM Jr (2002) Biodirected epitaxial nanodeposition of polymers on oriented macromolecular templates. Proc Natl Acad Sci USA 99:14009–14013
Kuga S, Takagi S, Brown RM Jr (1993) Native folded-chain cellulose II. Polymer 34:3293–3297
Laemmli U (1970) Cleavage of structural proteins during the assembly of the head of bacteriophage T4. Nature 227:680–685
Liu Y, Hu H (2008) X-ray diffraction study of bamboo fibers treated with NaOH. Fiber Polym 9:735–739
Morgan JLW, Strumillo J, Zimmer J (2013) Crystallographic snapshot of cellulose synthesis and membrane translocation. Nature 493:181–187
Nakai T, Sugano Y, Shoda M, Sakaibara H, Olwa K, Tuzi S, Imai T, Sugiyama J, Takeuchi M, Yamauchi D, Mineyuki Y (2013) Formation of a highly twisted ribbons in a carboxymethylcellulase gene-disrupted strain of a cellulose-producing bacterium. J Bacteriol 195:958–964
Nishi Y, Uryu M, Yamanaka S, Watanabe K, Kitamura N, Iguchi M, Mitsuhashi S (1990) The structure and mechanical-properties of sheets prepared from bacterial cellulose. Part 2: improvement of the mechanical properties of sheets and their applicability to diaphragms of electroacoustic transducers. J Mater Sci 25:2997–3001
Nobles D, Brown RM Jr (2008) Transgenic expression of Gluconacetobacter xylinus strain ATCC 53582 cellulose synthase genes in the cyanobacterium Synechococcus leopoliensis strain UTCC 100. Cellulose 15:691–701
Osborn MJ, Munson R (1974) Separation of the inner (cytoplasmic) and outer membranes of gram-negative bacteria. In: Fleisher S (ed) Methods in enzymology. Academic Press, New York, pp 642–653
Romling U, Gomelsky M, Galperin MY (2005) c-di-GMP: the dawning of a novel bacterial signaling system. Mol Microbiol 57:629–639
Ross P, Weinhouse H, Aloni Y, Michaeli D, Wienberger-Ohana P, Mayer R, Braun S, de Vroom E, van der Marel GA, van Boom JH, Benziman M (1987) Regulation of cellulose synthesis in Acetobacter xylinum by cyclic diguanylic acid. Nature 325:279–281
Ross P, Mayer R, Benziman M (1991) Cellulose biosynthesis and function in bacteria. Microbiol Rev 55:35–58
Saxena IM, Brown RM Jr (2005) Cellulose biosynthesis: current views and evolving concepts. Ann Bot 96:9–21
Saxena IM, Kudlicka K, Okuda K, Brown RM Jr (1994) Characterization of genes in the cellulose-synthesizing operon (acs operon) of Acetobacter xylinum: implications for cellulose crystallization. J Bacteriol 176:5735–5752
Saxena IM, Brown RM Jr, Fevre M, Geremia R, Henrissat B (1995) Multidomain architecture of glycosyl transferases: implications for mechanism of action. J Bacteriol 177:5276–5283
Schramm M, Hestrin S (1954) Factors affecting production of cellulose at the air/liquid interface of a culture of Acetobacter xylinum. J Gen Microbiol 11:123–129
Standal R, Iverson T, Coucheron DH, Fjaervik E, Blatny JM, Valla S (1994) A new gene required for cellulose production and a gene encoding cellulolytic activity in Acetobacter xylinum are colocalized with the bcs operon. J Bacteriol 176:665–672
Sunagawa N, Fujiwara T, Yoda T, Kawano S, Satoh Y, Yao M, Tajima K, Dairi T (2013) Cellulose complementing factor (Ccp) is a new member of the cellulose synthase complex (terminal complex) in Acetobacter xylinum. J Biosci Bioeng 115:607–612
Weinhouse H, Sapir S, Amikam D, Shilo Y, Volman G, Ohana P, Benziman M (1997) c-di-GMP-binding protein, a new factor regulating cellulose synthesis in Acetobacter xylinum. FEBS Lett 416:207–211
Yamanaka S, Watanabe K, Kitamura N, Iguchi M, Mitsuhashi S, Nishi Y, Uryu M (1989) The structure and mechanical properties of sheets prepared from bacterial cellulose. J Mater Sci 24:3141–3145
Yoshinaga F, Tonouchi N, Watanabe K (1997) Research progress in production of bacterial cellulose by aeration and agitation culture and its application as a new industrial material. Biosci Biotechnol Biochem 61:219–224
Zaar K (1979) Visualization of pores (export sites) correlated with cellulose production in the envelope of the gram negative bacterium Acetobacter xylinum. J Cell Biol 80:773–777
Author information
Authors and Affiliations
Corresponding author
Electronic supplementary material
Below is the link to the electronic supplementary material.
The wild type G. xylinus AY201 (MPG 16850 kb)
Time lapse videos of the acsDdm mutant (MPG 12282 kb)
10570_2014_521_MOESM6_ESM.tif
Full color colony morphology photomicrographs of the G. xylinus AY201 wild type (a–d) and acsDdm mutant (e-h) under bright-field (a, b, e, and f), polarization extinction (c and g) and first order red polarization (d and h) with scale bar representing 100 μm (a and e) and 25 μm (b-d and f-g) (TIFF 1414 kb)
10570_2014_521_MOESM8_ESM.tif
Negatively stained cellulose synthesized from individual cells with enlargements showing examples of the ribbons (a) and bundles of microfibrils within a ribbon (b) in the G. xylinus AY201 wild type; and the ribbons (c) and bundles of microfibrils within a ribbon (d) in the acsDdm mutant. Scale bar represents 25 nm (a and c) and 10 nm (b and c) (TIFF 526 kb)
10570_2014_521_MOESM9_ESM.tif
Examples of negatively stained cellulose synthesized by the G. xylinus AY201 wild type (a-h) and acsDdm mutant (i-p) that were used to obtain measurement data. Measurement bars were added for clarification. Scale bar represents 20 nm (a, b, e, f, 1, j, m, n) and 5 nm (c, d, g, h, k, o, l, and p) (TIFF 1154 kb)
10570_2014_521_MOESM10_ESM.tif
Negatively stained band material of the wild type G. xylinus AY201 all indicating linear TC orientation along the long axis of the cell (a-e). Arrows designate longitudinal orientation (b) on an enlarged version of the cell (a). Scale bar represents 0.5 μm (TIFF 665 kb)
10570_2014_521_MOESM11_ESM.tif
Negatively stained band material of the acsDdm mutant indicating various orientations of band material on the cell. Arrows designate transverse orientation on one cell (a); transverse and longitudinal orientation on the same cell (b); transverse only (c); transverse and longitudinal (d); and diagonal orientation (e). Scale bar represents 0.5 μm (TIFF 525 kb)
10570_2014_521_MOESM12_ESM.tif
Phase contrast of the wild type G. xylinus AY201 (a and b) and the acsDdm mutant (c and d) scale bar represents 10 um. Average cell dimensions (e) (TIFF 262 kb)
10570_2014_521_MOESM13_ESM.tif
Schematic illustrations of the observed movement due to possible linear TC orientation in the wild type G. xylinus AY201 (a) and the acsDdm mutant (b) (TIFF 144 kb)
10570_2014_521_MOESM14_ESM.tif
Schematic diagram of an example of linear TC arrangement which could result in reduced cellulose biosynthesis. Liner TC orientation along the longitudinal axis of the cell (a); linear TC orientation transverse to the long axis (b); movement of the cell parallel to the long axis (c); movement of the cell perpendicular to the long axis (d); and possible circular movement of the cell as both directional forces are combined (e) (TIFF 56 kb)
10570_2014_521_MOESM15_ESM.tif
Negatively stained band material synthesized at room temperature under agitated conditions by the wild type G. xylinus (a) and the acsDdm mutant (b). Scale bar represents 0.5 μm (TIFF 561 kb)
Rights and permissions
About this article
Cite this article
Mehta, K., Pfeffer, S. & Brown, R.M. Characterization of an acsD disruption mutant provides additional evidence for the hierarchical cell-directed self-assembly of cellulose in Gluconacetobacter xylinus . Cellulose 22, 119–137 (2015). https://doi.org/10.1007/s10570-014-0521-y
Received:
Accepted:
Published:
Issue Date:
DOI: https://doi.org/10.1007/s10570-014-0521-y




